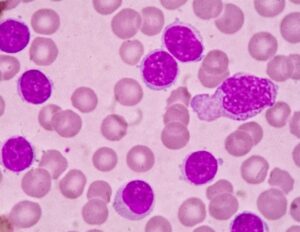
Νέα θεραπεία υπόσχεται ελπίδα για ασθενείς με χρόνια λεμφοκυτταρική λευχαιμία

Την 7η Κρητική Ρακοβραδιά διοργανώνουν ο Σύλλογος Κρητών Ραφήνας – Πικερμίου και η Αδελφότητα Ηπειρωτών Ν. Μάκρης – Μαραθώνα – Ραφήνας. Τη Κυριακή 4 Σεπτεμβρίου 202 και ώρα 20:30 σας περιμένουν στο Πάρκο Καραμανλή όπου θα πραγματοποιηθεί η εκδήλωση. Καλεσμένοι θα είναι ο Κρητικός Λυράρης Νίκος Ζωϊδάκης συνοδευόμενος από τον Δημήτρη Υφαντή.
Καθ’ όλη τη διάρκεια της εκδήλωσης θα διατίθενται παραδοσιακά εδέσματα της Κρήτης και της Ηπείρου όπως γραβιέρα, γαμοπίλαφο, παξιμάδια, τσικουδιά, ηπειρώτικες πίτες (Κασιόπιτα, Κρεατόπιτα, Χορτόπιτα, Μακαρονόπιτα και Μπλατσαριά), αλλά και σουβλάκια, κρασί και μπύρες.














